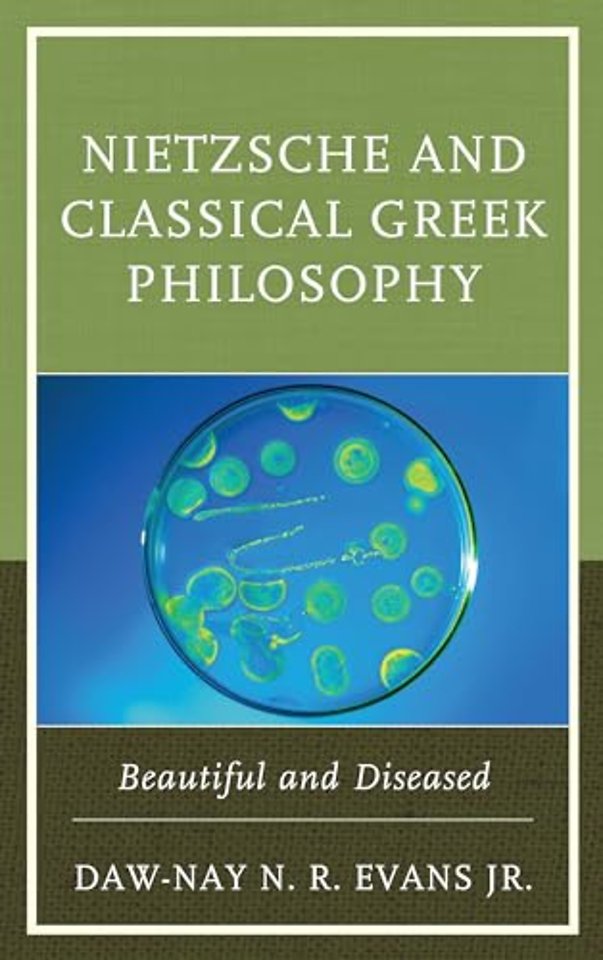
Nietzsche and Classical Greek Philosophy
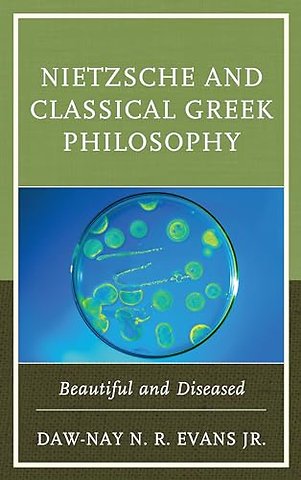

Nietzsche and Classical Greek Philosophy
Beautiful and Diseased
Samenvatting
This book presents a new understanding of Nietzsche’s view of Socrates, Plato, and Aristotle. Through a careful study of how these philosophers appropriate reason in both life-negating and life-affirming ways, Daw-Nay N. R. Evans Jr. offers a fresh perspective on Nietzsche and classical Greek philosophy.
Specificaties
Net verschenen
Rubrieken
- aanbestedingsrecht
- aansprakelijkheids- en verzekeringsrecht
- accountancy
- algemeen juridisch
- arbeidsrecht
- bank- en effectenrecht
- bestuursrecht
- bouwrecht
- burgerlijk recht en procesrecht
- europees-internationaal recht
- fiscaal recht
- gezondheidsrecht
- insolventierecht
- intellectuele eigendom en ict-recht
- management
- mens en maatschappij
- milieu- en omgevingsrecht
- notarieel recht
- ondernemingsrecht
- pensioenrecht
- personen- en familierecht
- sociale zekerheidsrecht
- staatsrecht
- strafrecht en criminologie
- vastgoed- en huurrecht
- vreemdelingenrecht